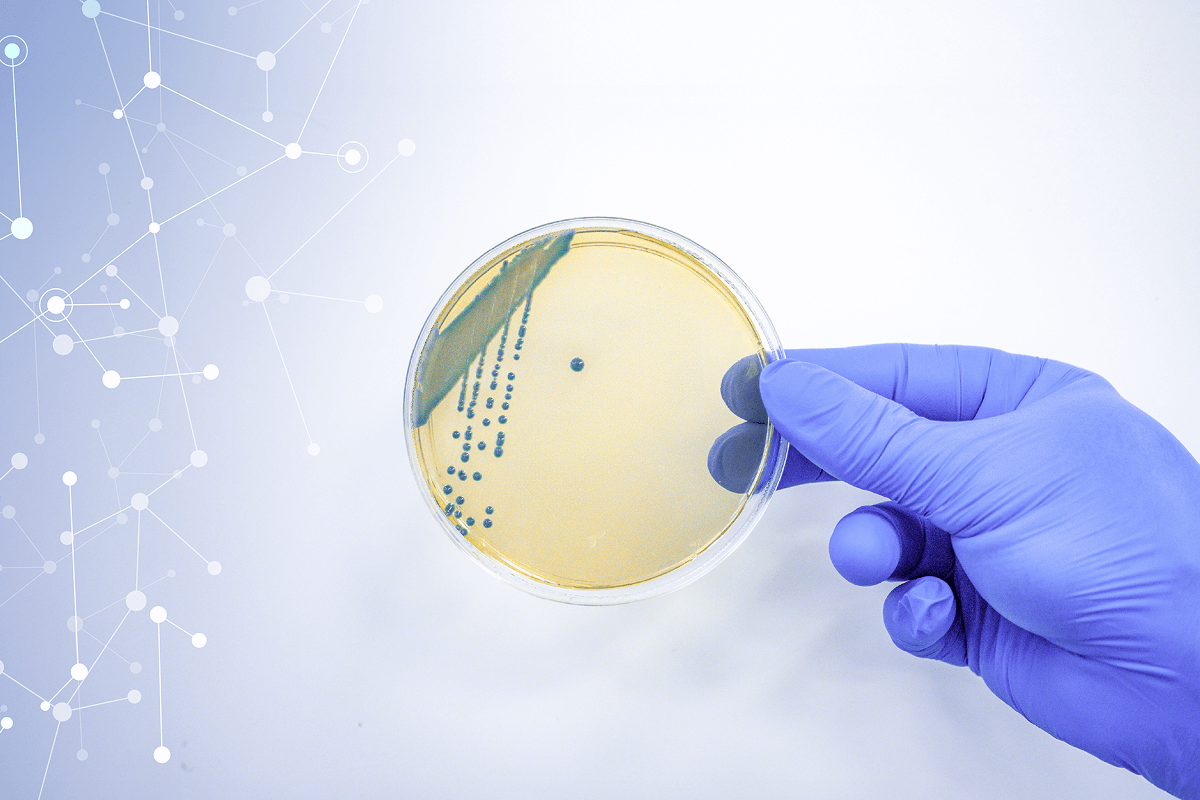

Чому антибіотики стають усе менш ефективними та чим це загрожує
Лілія Пащак,
завідувачка відділу бактеріології лабораторії "Сінево"
"Антибіотикорезистентність виникає, коли бактерії змінюються так, що антибіотики стають неефективними. І це глобальна загроза здоров’ю, яка може повернути медицину до часів, коли навіть незначна рана може призвести до летальних випадків".
Головною, але далеко не єдиною причиною стійкості бактерій до антибіотиків, як каже фахівчиня, є
необґрунтоване вживання хворим медпрепаратів – тоді, коли вони не потрібні або коли людина приймає антибіотики через невмотивовані лікарські призначення.
"Багато людей намагаються пропити препарати навіть за звичайного ГРВІ, щоб одужати швидше або знизити ризик ускладнень. Насправді користі від такого рішення не буде, а от нашкодити собі можна. У більшості клінічних ситуацій перед призначенням антибіотика доцільно скеровувати пацієнта на бактеріологічні дослідження (посів, антибіотикограму), щоб підібрати терапію, спрямовану саме проти збудника, який є причиною виникнення тих чи інших клінічних симптомів. Якщо стан критичний і рішення треба ухвалювати негайно, щонайменше варто виконати базові лабораторні тести (наприклад, аналіз крові), аби обґрунтувати антибактеріальне лікування", – пояснює Лілія Пащак.
Важливість проводити дослідження перед призначенням антибіотиків підтверджує Йовенко Ігор Олександрович – лікар-анестезіолог, завідувач відділення анестезіології та інтенсивної терапії Медичного дому Odrex, кандидат медичних наук, доцент кафедри анестезіології та інтенсивної терапії ОНМедУ, заслужений лікар України.
Ігор Олександрович:
"Антибіотики потрібно призначати пацієнту тільки за наявності бактеріальної інфекції або для її профілактики перед оперативним втручанням і при деяких серйозних травмах. Призначення антибіотиків в медицині регламентовано наказами, протоколами та клінічними рекомендаціями. Висновок про наявність інфекції робить кваліфікований лікар. Не можна призначати антибіотики без консультації фахівця".
Для того щоб відрізнити бактеріальну інфекцію від вірусної, за словами лікаря-анестезіолога, необхідно знати історію пацієнта про початок і розвиток хвороби, провести огляд пацієнта та спеціальні лабораторні тести, які можуть бути швидкими (експрес-тексти) або потребувати певного часу. Тільки після отримання сукупності цих даних лікар може призначити старт антибактеріальної терапії.
"Бактеріологічні дослідження – надзвичайно і принципово важливі для цілеспрямованого і більш ефективного лікування бактеріальних інфекцій, бо дають лікарю інформацію про мікроорганізм, який викликав інфекцію, його особливості та чутливість до антибіотиків. Своєчасні й швидкі бактеріологічні дослідження – запорука ефективного лікування інфекцій", – підкреслює Ігор Олександрович.
Неправильний вибір антибіотика та неправильний підрахунок дозування сприятиме посиленню антибіотикорезистентності. Окрім того, бактерії мутують, коли пропустити навіть 1–2 дози препарату або закінчити приймання ліків завчасно.
"Вживання антибіотика не можна переривати. Якщо, наприклад, курс лікування 5–7–10 днів, але на третій день хворому стало краще, то антибіотик потрібно приймати далі. Через ситуації, коли пацієнти самовільно припиняють лікування, бактерії стають агресивні, гени мутують і набувають резистентності. І наступного разу, коли хворий знову буде лікуватися таким антибіотиком, препарат може вже не допомогти", – пояснює пані Лілія.
Особливу тривогу викликає призначення лікарями пацієнтам антибіотиків останнього покоління.
"На жаль, в Україні часто трапляється, коли пацієнту одразу призначається антибактеріальний препарат «останньої лінії», наприклад, на основі колістиметату натрію. Це потужний антибіотик, який за кордоном відсутній у призначеннях для звичайного лікування. Адже після застосування одразу такого серйозного препарату хворому потім вже нічого не допомагає", – наголошує Лілія Пащак.
Ба більше, за словами пані Лілії, мутовані патогени є загрозою не лише для однієї людини, вони можуть легко поширюватися, викликаючи аналогічні проблеми й в інших людей. Їхня передача відбувається звичайними шляхами інфікування: повітряно-крапельним, побутовим або контактним.
пані Лілія підкреслює:
"Є такі мікроорганізми, які передаються через шкіру, їжу, предмети спільного користування. В часи війни, коли нерідко обмежений доступ до чистої води та засобів гігієни, все це створює умови для швидкого поширення інфекції".